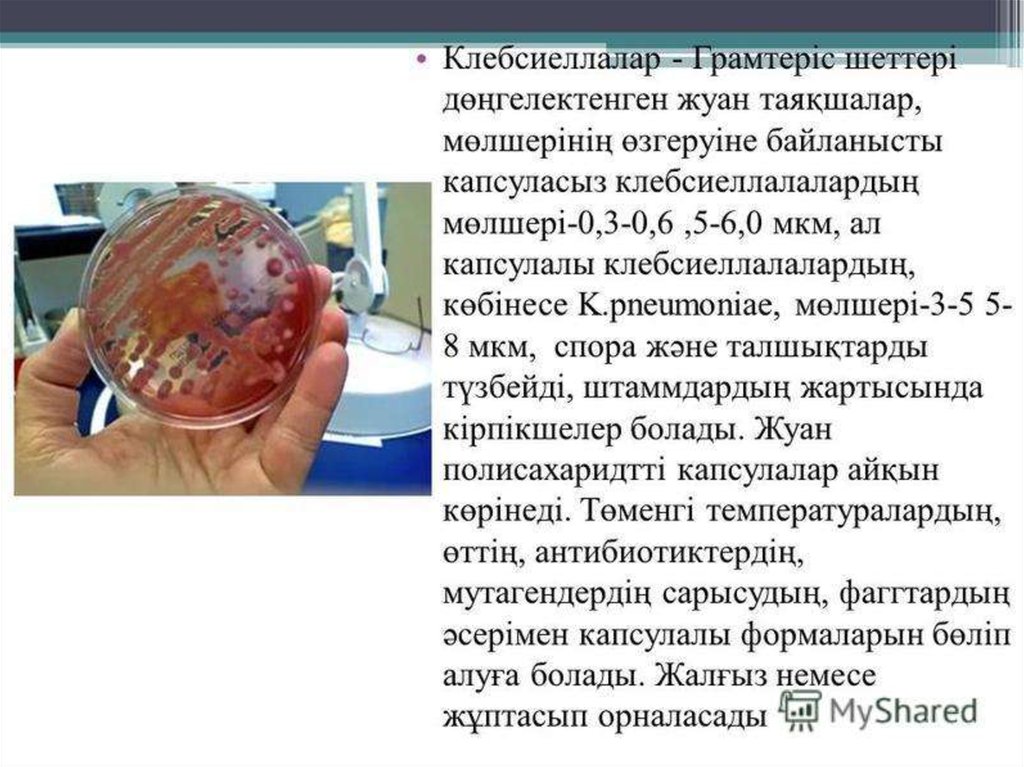

Similar presentations:
Клебсиеллалар патогенділігі. Этиологиялық патогендік рөлі. Экологиясы. Ауруханаішілік инфекция дамуындағы рөлі
1.
Тақырыбы: Клебсиеллалар патогенділігі. Этиологиялықпатогендік рөлі. Экологиясы. Ауруханаішілік инфекция
дамуындағы рөлі. Лабораториялық анықтауы. Алдын алу
және емдеу
Орындаған : Шиналиева Аида
Қабылдаған: Кеулімжаева А.Е.
Тобы: 204 Б
Ақтөбе- 2018 ж.ж.

medicine
medicine








